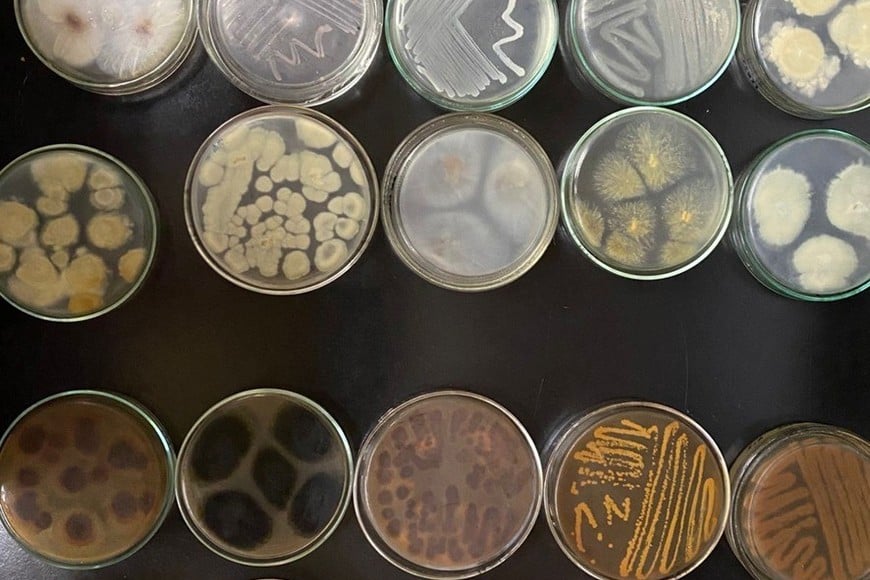
Algunos microorganismos mostraron una alta tolerancia a metales pesados como cromo, arsénico y plomo.

Con el objetivo de extender la vida útil del relleno sanitario de la ciudad Santa Fe y mitigar los riesgos ambientales que representan los lodos generados por el tratamiento de lixiviados, un equipo de investigación de la Universidad Nacional del Litoral (UNL) y el Conicet, desarrolló un proyecto basado en estrategias de remediación biológica.
Utilizan plantas y microorganismos para remediar lodos de la planta de tratamiento de residuos
El proyecto liderado por la docente e investigadora María Eugenia Lovato se enfoca en el tratamiento de lixiviados contaminados con metales pesados. Ya se encuentra en su etapa final y evalúan su aplicación a escala local y regional.

La iniciativa es dirigida por la docente e investigadora María Eugenia Lovato, doctora en Ingeniería Química, que desarrolla sus tareas en el Instituto de Desarrollo Tecnológico para la Industria Química (Intec-UNL-Conicet) y se desempeña como docente de la Facultad de Ingeniería Química (FIQ-UNL).
"Lo que se estudió fue la remediación de los lodos generados en la planta de tratamiento de lixiviados del relleno sanitario municipal. Actualmente, esos lodos se vuelven a depositar en las celdas del relleno, ocupando espacio y disminuyendo su vida útil. Nosotros propusimos una estrategia de remediación biológica para poder sanearlos y darles otro uso dentro del mismo predio", explicó Lovato al diario El Litoral.
El proyecto de investigación se realiza desde hace 4 años en el marco de un Proyecto CAI+D Orientado, de la UNL, que buscan generar conocimiento y aportar soluciones a problemáticas específicas de la comunidad y el desarrollo sostenible de la región.

Plantas ornamentales y de cobertura
La investigación se basó en dos líneas principales: la fitorremediación, utilizando plantas, y la biorremediación microbiana, empleando microorganismos aislados del propio sitio contaminado.
En el caso de las plantas, se seleccionaron especies tolerantes a los contaminantes presentes en los lodos. "Encontramos que especies ornamentales como un tipo de tabaco -que no es el de consumo, sino uno ornamental-, gramíneas parecidas al césped y plantas que crecen de forma espontánea en el relleno, son capaces de crecer en ese lodo y de extraer contaminantes del suelo", señaló.
Según Lovato, esta línea de trabajo permitiría, a futuro, usar estas especies en la etapa de cierre del relleno. "Hoy en día, cuando se clausura una celda, se le aplica una capa de tierra. Con estos estudios, surge la posibilidad de emplear una mezcla de tierra con lodo tratado y sembrar esas plantas, lo que le daría un valor estético y ambiental al sitio del relleno".
Microorganismos que resisten metales pesados
La otra estrategia fue la remediación mediante microorganismos. "Pudimos aislar bacterias, actinobacterias y mohos del propio sitio. Algunas de estas cepas mostraron una alta tolerancia a metales pesados como cromo, arsénico y plomo, incluso cuando están presentes más de uno al mismo tiempo. También armamos consorcios microbianos -que son combinaciones de varias especies- para aprovechar el potencial que tiene cada uno", indicó la investigadora.
Además, Lovato y su equipo estudiaron la capacidad de estos microorganismos para sobrevivir y transformar los metales. "Determinamos algunas actividades enzimáticas que les permiten metabolizar estos compuestos y, en algunos casos, cambiar el estado de oxidación de los metales, haciéndolos menos tóxicos", agregó.

Aplicación y cooperación
El proyecto fue desarrollado en cooperación con la empresa operadora del relleno, que facilitó el acceso a muestras y monitoreos. La idea es que las estrategias de remediación se apliquen in situ. "El uso de los lodos se plantea dentro del relleno, que ya está preparado con coberturas e impermeabilización. No se busca trasladarlos a otro lado", aclaró Lovato.
Al relleno sanitario de la ciudad de Santa Fe llega un promedio de basura diaria de 14 mil toneladas. De ese total, sólo un 5% se procesa en planta de selección, es decir, del recupero de material reciclable y, por tanto, comerciable y vendible (plásticos, papel y cartón, electrónicos, vidrio, etcétera).
Los resultados del estudio ya generaron múltiples producciones científicas. Lovato indicó que "dieron origen a una tesis doctoral finalizada, otra que está en marcha, dos tesinas de grado en Biotecnología y varias becas de iniciación a la investigación". También se publicaron artículos en revistas científicas internacionales que validaron la originalidad del enfoque.
Sobre la posibilidad de avanzar hacia una implementación concreta, la investigadora anticipó que ya se está evaluando con la empresa la idea de "poder generar plantines de las especies tolerantes para utilizarlos en las operaciones de clausura del relleno, a medida que se vayan cerrando las celdas. Ya lo venimos conversando".
Desafíos
-En el marco del contexto actual de la ciencia, ¿están pudiendo sostener este proyecto?
-Muchos subsidios que teníamos para algunos proyectos no están recibiendo fondos. Este en particular fue posible gracias al financiamiento de la UNL, que nos permitió avanzar desde hace aproximadamente cuatro años. Fuimos estudiando diferentes aristas del problema y es un interés del grupo de trabajo seguir desarrollando esta tecnología para que efectivamente se pueda implementar.









